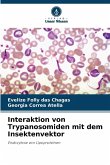
Interaktion von Trypanosomiden mit dem Insektenvektor

Das Cherry leaf roll virus (CLRV) der Gattung Nepovirus ist weltweit in einer Vielzahl krautiger und holziger Wirtspflanzenarten vertreten. Die natürliche Verbreitung kann vertikal durch Saatgut und horizontal durch Pollen erfolgen. Das CLRV-Transportprotein (MP) gehört zur Familie der 30 K-Proteine, so dass der Transport in Partikelform entlang tubulärer Strukturen aus multimerisierten MP über modifizierte Plasmodesmata erfolgt. Im Rahmen dieser Arbeit wurden mit dem Yeast Two-Hybrid System (YTHS) erstmals potentiell funktionelle Domänen des CLRV-Transportproteins (MP) identifiziert, für den Transport essentielle Interaktionen der CLRV-Proteine gezeigt und pflanzliche Interaktionspartner im Virus-Wirt-System CLRV-A. thaliana isoliert. Wechselwirkungen mit Wirtsproteinen können sowohl in der erfolgreichen Vermittlung des Virustransports als auch an der Reaktion der Pflanze auf den Virusbefall beteiligt sein.
Bitte wählen Sie Ihr Anliegen aus.
Rechnungen
Retourenschein anfordern
Bestellstatus
Storno